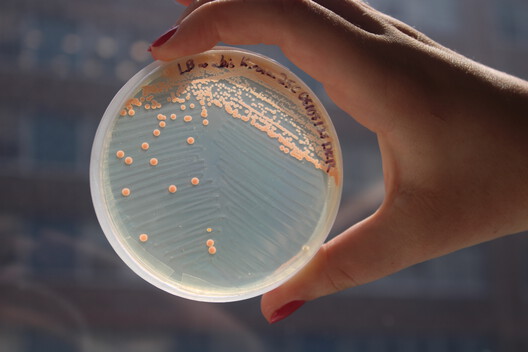
The Architect as Mediator of Materials: Lessons from Hybrid Habitats - Image 7 of 7

With deep roots, sturdy trunks, and the ability to withstand extreme temperatures, date palms (Phoenix dactylifera) are among the species best adapted to the arid desert environment. It is no coincidence that in many local indigenous cultures they are known as the "tree of life," as their fruits, leaves, and trunks have provided food, shelter, and building materials for thousands of years. Without them, much of human settlement in desert regions would not have been possible. Today, widely cultivated across desert regions around the world, the species continues to sustain traditional agricultural practices, yet its potential can be further enhanced and expanded through the efforts of contemporary researchers.
Dr. Sandra Piesik's research investigates how vernacular materials can take new directions in architecture, bridging technology and ecological systems. Her long-standing inquiry into the cultural and material role of date palms has evolved into Hybrid Habitats, a design initiative developed at Pratt Institute and presented at the Biodesign Challenge 2025. Rooted in desert ecologies and the urgent realities of climate change, the project positions architects as mediators, connecting tradition and biotechnology, local communities and global networks.
"After graduating from the Architectural Association in London, I moved to Dubai, where my journey with date palms began," Piesik recalls. "I discovered that date palm leaves had been used in the construction of cities for around 7,000 years, creating a bio-circular economy model, which sparked my interest in exploring their material properties." This journey led to the publications Arish: Palm Leaf Architecture and Habitat: Vernacular Architecture for a Changing Climate, and now to Hybrid Habitats.
Related Article
Zero Waste in Architecture: Rethink, Reduce, Reuse and Recycle
This studio, practice, and laboratory seeks to demonstrate how agricultural by-products, specifically date palm leaves, can be reinvented as building systems in response to desertification, drought, and extreme heat. The project explored reflective facades, modular canopies, and microbial biohues, all designed to modulate sunlight, temperature, and environmental responsiveness. It also redefines the position of architecture within broader systems. "Hybrid Habitats provides a platform for transferring vernacular materials and knowledge across bioregions, in alignment with the planet's diverse climate zones," says Piesik. "Our mission is to merge low-tech traditional methods with cutting-edge technologies, enhancing material performance while fostering stylistic innovation."
Collaboration Across Disciplines
Four projects explore different applications of biotechnology in response to extreme environmental conditions. Form Finding BioHue is a modular system that can function as a facade or as a stand-alone habitat for passive cooling. Made from palm dust combined with color-changing bacteria and applied over bioplastic or eco-concrete, it will be implemented first in the deserts of India and adapted globally, empowering women and fostering a bio-circular economy. Geometric Explorations Palm Shade proposes parametric shading structures that incorporate local materials and leverage the UV-resistant properties of bacteria, serving as additions to existing buildings in California's Coachella Valley. Organic Motion K-Biotic Reflector, designed for the MENA region, combines date palm leaves and mushroom mycelium to create reflective facades that modulate heat and light, rotating in response to the sun. Finally, Modularity Desert Canopy, developed for the Sonoran Desert, presents lightweight modular canopy systems that generate habitable microclimates in arid regions. These canopies function simultaneously as heat reflectors and ventilation devices, while bacteria growing beneath the panels help regulate moisture.

Developed in collaboration with the Dietrich Lab at Columbia University and students of architecture, landscape, and microbiology, the project flourished within what Piesik calls a culture of "YES," the willingness to test, fail, and try again. "The processes of testing, observing results, monitoring material behavior, and advancing step by step are classic approaches that drive both practical experimentation and scientific analysis," she observes.
For students, this cross-pollination proved transformative. Bhavya Manish Prajapati, Mithila Sunil Patil, and Falguni Sakpal recall: "Our journey with BioHue focused on experimenting with materials and designing specifically for different climates… learning biological behavior as a design input and creating a passive cooling system with living materials." Anand Popat, who developed the K-Biotic Heat Reflector alongside Lucius Hu and Kayla J. Reyes, explored the combination of dried date palm leaves with mushroom mycelium to create an innovative composite capable of protecting buildings from extreme heat. Microbiologist Dr. Lars Dietrich, in turn, highlighted the impact of such collaborations: "The experience opened my eyes to the possibilities at the intersection of fundamental science, design, and art, where visually striking concepts can also offer real societal benefits."

Toward Biotechnological Equity
Perhaps the most significant aspect of the initiative is Piesik's emphasis on biotechnological equity, a concept that links design innovation to sustainable livelihoods. "In practical terms, it means empowering communities in desert regions to pursue economic development and build sustainable livelihoods," she explains. In this sense, equity also means amplifying the voices of women in academia, architectural practice, and community decision-making. Hybrid Habitats also aligns with the United Nations Sustainable Development Goals (SDGs), particularly Goals 9 (Industry, Innovation and Infrastructure), 11 (Sustainable Cities and Communities), 13 (Climate Action), and 15 (Life on Land), and is already preparing a prototyping initiative in California, where date palms are abundant. At the same time, she is formalizing the Hybrid Habitats Bioregional Collaboration.


For Piesik, the role of the architect in the future is not only to design structures but to mediate between materials, knowledge, and ecosystems. "We are pioneering a resource-oriented approach that aligns with the ecosystems and climate zones of the planet, reflecting the order of habitats humanity has maintained for twelve thousand years while sustaining ecological equilibrium." The ancient Arab proverb, "Who plants dates, doesn't harvest dates," reminds us that true contributions are measured by what we leave for future generations. In this spirit, the initiative points to a future where preserving, transmitting, and reinventing local knowledge becomes both a strategy for resilience and an expression of generosity.
Students Involved:
Form Finding BioHue: Bhavya Manish Prajapati, Mithila Sunil Patil, Falguni Sakpal
Geometric Explorations Palm Shade: Alara Ata, Andreas Palfinger, Aysin Bahar Sahin
Organic Motion K-Biotic: Anand P. Popat, Kayla J. Reyes, Lucius Hu
Modularity Desert Canopy: Ren Henniger, Rundong Ying
Dietrich Lab Students: Griffin Gowdy, Riley McGarrigle, Devin Thomas King-Roberts, Meredith Alderman, Neil Bajau, Enkang Jiang, Aresti Monovoukas, Summer Qureshi, Erika Tanig
This article is part of the ArchDaily Topics: Architecture Without Limits: Interdisciplinarity and New Synergies. Every month we explore a topic in-depth through articles, interviews, news, and architecture projects. We invite you to learn more about our ArchDaily Topics. And, as always, at ArchDaily we welcome the contributions of our readers; if you want to submit an article or project, contact us.